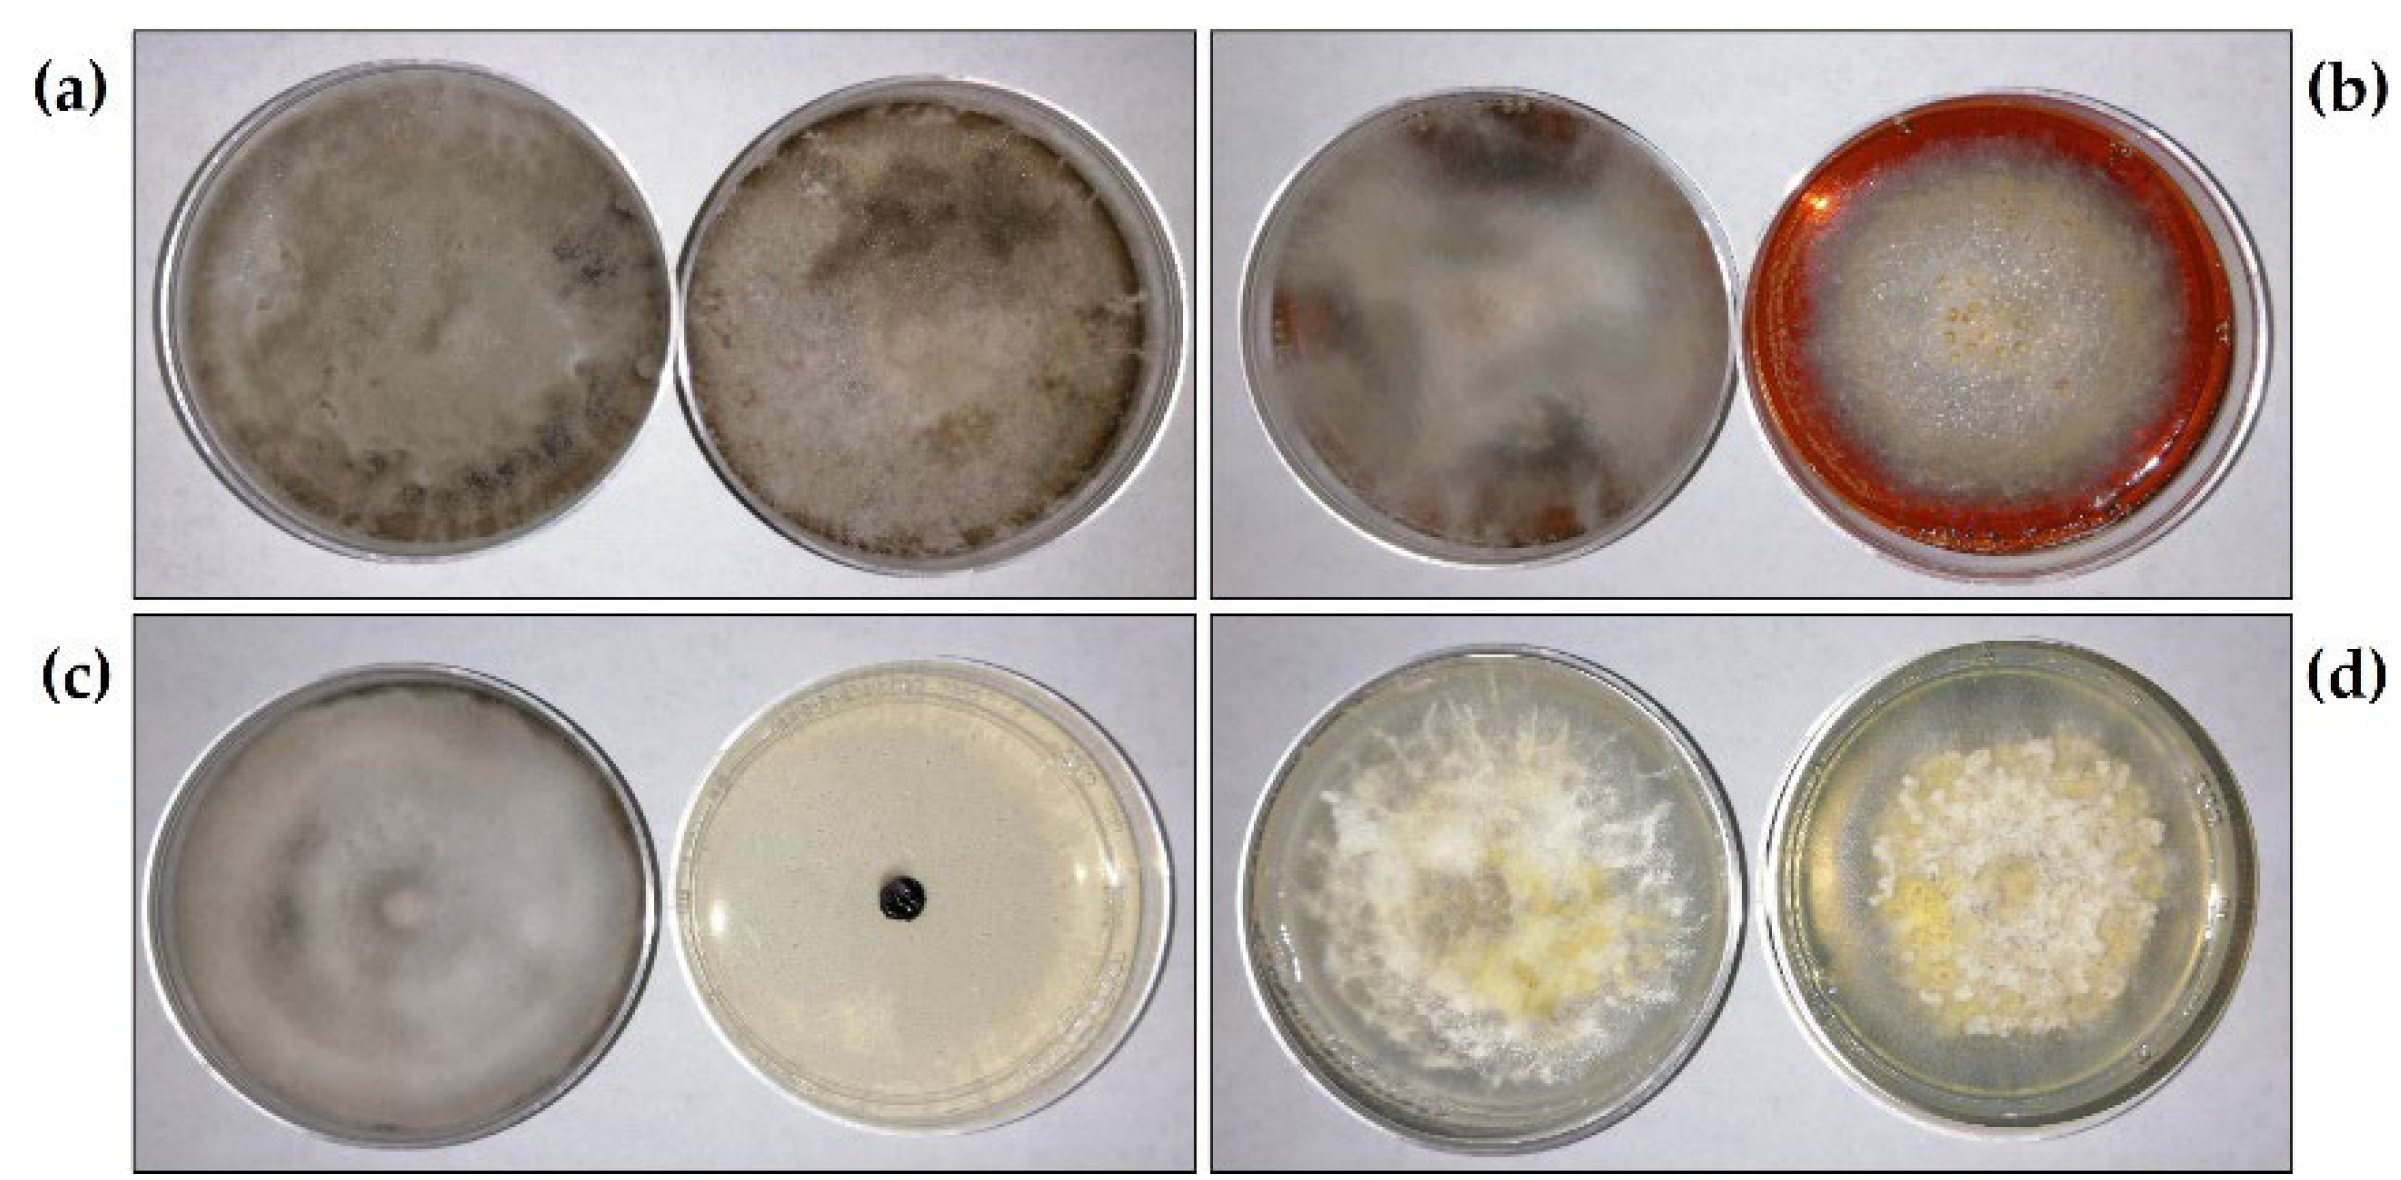
Plants 11 02821 g002
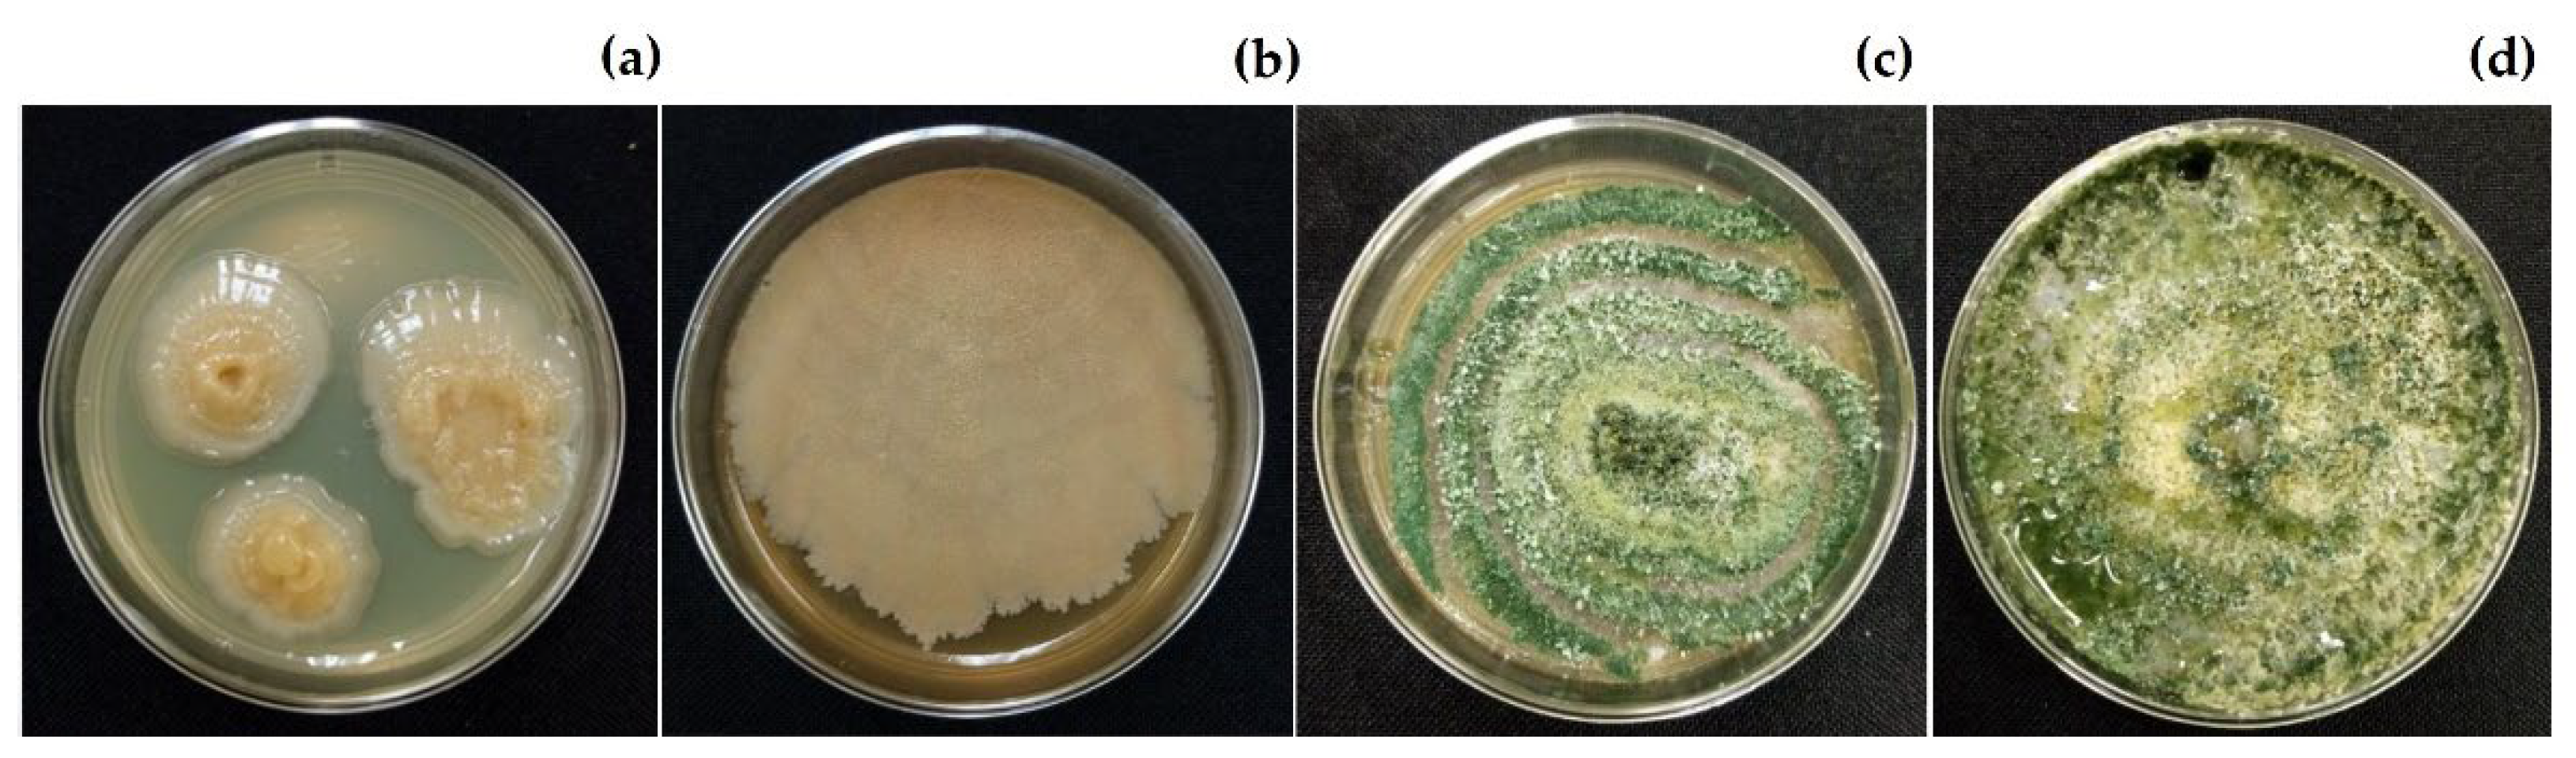
Plants 11 02821 g007

Activity of Aqueous Extracts from Native Plants of the Yucatan Peninsula against Fungal Pathogens of Tomato In Vitro and from Croton chichenensis against Corynespora cassiicola on Tomato
Abstract
1. Introduction
2. Results
2.1. Identification of Fungal Phytopathogens
2.2. Antifungal In Vitro Activity of Aqueous Extracts
2.3. Corynespora cassiicola–Solanum lycopersicum Pathosystem
2.3.1. Logarithmic–Diagrammatic Scale Development
2.3.2. Validation of Logarithmic–Diagrammatic Scale
2.4. In Vivo Effect of Extract from Croton chichenensis on Tomato Leaf Spot
2.5. Phytotoxicity of Croton chichenensis Roots
2.6. Compatibility of Croton chichenensis Extract and Beneficial Organisms
3. Discussion
4. Materials and Methods
4.1. Isolation and Pathogenicity Tests of Phytopathogenic Fungi
4.2. Identification of the Fungi
4.3. Plant Material
4.4. Preparation of Aqueous Extracts
4.5. In Vitro Antifungal Bioassay of Aqueous Extracts
4.5.1. Inhibition of Mycelial Growth
4.5.2. Inhibition of Sporulation
4.5.3. Inhibition of Spore Germination
4.5.4. Statistical Analyses
4.6. Pathosystem Corynespora cassiicola—Solanum lycopersicum
4.6.1. Development of the Logarithmic—Diagrammatic Scale
4.6.2. Validation of the Logarithmic—Diagrammatic Scale
4.7. Evaluation of Croton chichenensis Extract on Tomato Leaf Spot
4.7.1. Tomato Crops and Infection with Corynespora cassiicola
4.7.2. Epidemiological Parameters
4.8. Phytotoxicity Bioassay on Solanum lycopersicum Leaf
4.9. In Vitro Compatibility Bioassay with Beneficial Organisms
5. Conclusions
Author Contributions
Funding
Institutional Review Board Statement
Informed Consent Statement
Data Availability Statement
Acknowledgments
Conflicts of Interest
References
- Jiménez, M.F.; Carrasco, H.; Olea, A.F.; Silva, E. Natural compounds: A sustainable alternative to the phytopathogens control. J. Chil. Chem. Soc. 2019, 64, 4459–4465. [Google Scholar] [CrossRef]
- Romani, A.; Simone, G.; Campo, M.; Moncini, L.; Bernini, R. Sweet chestnut standardized fractions from sustainable circular process and green tea extract: In vitro inhibitory activity against phytopathogenic fungi for innovative applications in green agriculture. PLoS ONE 2021, 16, e0247298. [Google Scholar] [CrossRef]
- Fungicide Resistance Action Committee, FRAC. Available online: https://fmcagro.es/blog/ver-entrada/clasificaci%C3%B3ndelosmodosdeacci%C3%B3ndeFRACeIRAC (accessed on 18 July 2022).
- Shuping, D.S.S.; Eloff, J.N. The use of plants to protect plants and food against fungal pathogens: A review. Afr. J. Tradit. Complementary Altern. Med. 2017, 14, 120–127. [Google Scholar] [CrossRef] [PubMed]
- Ribera, A.E.; Zuñiga, G. Induced plant secondary metabolites for phytopatogenic fungi control: A review. J. Soil. Sci. Plant Nutr. 2012, 12, 893–911. [Google Scholar] [CrossRef]
- Masoko, P.; Eloff, J.N. The diversity of antifungal compounds of six South African Terminalia species (Combretaceae) determined by bioautography. Afr. J. Biotechnol. 2005, 4, 1425–1431. Available online: https://www.ajol.info/index.php/ajb/article/view/71476 (accessed on 17 July 2022).
- Ahmad, K.; Ali, A.; Afridi, W.A.; Somayya, R.; Ullah, M.J. Antimicrobial, hemagglutination and phytotoxic activity of crude ethanolic and aqueous extracts of Seriphidium kurramense. J. Tradit. Chin. Med. 2018, 38, 433–438. Available online: https://pubmed.ncbi.nlm.nih.gov/32185977/ (accessed on 5 July 2022). [CrossRef]
- Ladhari, A.; Omezzine, F.; DellaGreca, M.; Zarrelli, A.; Zuppolini, S.; Haouala, R. Phytotoxic activity of Cleome arabica L. and its principal discovered active compounds. South Afr. J. Bot. 2013, 88, 341–351. [Google Scholar] [CrossRef]
- Villaseñor, J.L. Checklist of the native vascular plants of México. Rev. Mex. De Biodivers. 2016, 87, 559–902. [Google Scholar] [CrossRef]
- Ramírez-Morillo, I.M. La flora de la península de Yucatán: ¿Diversa? ¿Bien conocida? ¿Protegida? No, no y ¿No? Desde Herb. CICY 2019, 11, 130–137. [Google Scholar]
- Peraza-Sánchez, S.R.; Chan-Che, E.O.; Ruiz-Sánchez, E. Screening of Yucatecan plant extracts to control Colletotrichum gloeosporioides and isolation of a new pimarene from Acacia pennatula. J. Agric. Food Chem. 2005, 53, 2429–2432. [Google Scholar] [CrossRef]
- Gamboa, M.; Cristóbal, J.; Medina, I.L.; Chí, F.; Méndez, R.; Simá, P.; May, F. Antifungal properties of selected plants from the Yucatan península, México. World J. Microbiol. Biotechnol. 2008, 24, 1955–1959. [Google Scholar] [CrossRef]
- Moo, F.A.; Cristóbal, J.; Reyes, A.; Tun, J.M.; Sandoval, R.; Ramírez, J.A. Actividad in vitro del extracto acuoso de Bonellia flammea contra hongos fitopatógenos. Agrociencia 2014, 48, 833–845. Available online: https://agrociencia-colpos.org/index.php/agrociencia/article/view/1123/1123 (accessed on 27 May 2022).
- Vargas, A.A.; Gamboa, M.M.; Medina, I.L.; Pérez, D.; Cristóbal, J.; Ruiz, E. Evaluación de extractos de plantas nativas yucatecas contra Alternaria chrysanthemi y espectro de actividad antifúngica de Acalypha gaumeri. Rev. Mex. Fitopatol. 2014, 32, 1–11. Available online: https://www.researchgate.net/publication/317441366_Evaluacion_de_Extractos_de_Plantas_Nativas_Yucatecas_Contra_Alternaria_chrysanthemi_y_Espectro_de_Actividad_Antifungica_de_Acalypha_gaumeri?enrichId=rgreq-cb1c696aa8831adfcf83e29575e415bc-XXX&enrichSource=Y292ZXJQYWdlOzMxNzQ0MTM2NjtBUzo1MTcwOTQzMDU2NjUwMjlAMTUwMDI5NjI5NzYyMQ%3D%3D&el=1_x_3&_esc=publicationCoverPdf (accessed on 22 June 2022).
- Cruz, P.; Cristóbal, J.; Ruiz, V.; Carnevali, G.; Vera, M.; Martín, J.; Reyes, F.; Gamboa-Angulo, M. Extracts from six native plants of the Yucatán peninsula hinder mycelial growth of Fusarium equiseti and F. oxysporum, Pathogens of Capsicum chinense. Pathogens 2020, 9, 827. [Google Scholar] [CrossRef]
- Vargas, A.A.; Cristóbal, J.; Canto, B.; Gamboa, M.M. Aqueous extracts from Acalypha gaumeri and Bonellia flammea for leaf blight control in chrysanthemum (Chrysanthemum morifolium). Rev. Mex. Fitopatol. 2022, 1, 40–58. [Google Scholar] [CrossRef]
- MacKenzie, K.J.; Sumabat, L.G.; Xavier, K.V.; Vallad, G.E. A review of Corynespora cassiicola and its increasing relevance to tomato in Florida. PHP 2018, 19, 303–309. [Google Scholar] [CrossRef]
- Ma, D.; Zhu, J.; Jiang, J.; Zhao, Y.; Li, B.; Mu, W.; Liu, F. Evaluation of bioactivity and control efficacy of tetramycin against Corynespora cassiicola. Pestic. Biochem. Physiol. 2018, 152, 106–113. [Google Scholar] [CrossRef]
- Wani, A.H. An overview of the fungal rot of tomato. Mycopath 2011, 9, 33–38. Available online: http://pu.edu.pk/images/journal/impp/PDF-FILES/8-FINALReview%20AH%20WANI%2017-5-2012_vol%209(1)2011.pdf (accessed on 30 June 2022).
- Griffiths, S.A.; Cox, R.J.; Overdijk, E.J.R.; Mesarich, C.H.; Saccomanno, B.; Lazarus, C.M.; De Wit, P.J.G.M.; Collemare, J. Assignment of a dubious gene cluster to melanin biosynthesis in the tomato fungal pathogen Cladosporium fulvum. PLoS ONE 2018, 13, e0209600. [Google Scholar] [CrossRef]
- Ni, L.; Punja, Z.K. Management of fungal diseases on cucumber (Cucumis sativus L.) and tomato (Solanum lycopersicum L.) crops in greenhouses using Bacillus subtilis. In Bacilli and Agrobiotechnology: Phytostimulation and Biocontrol; Islam, T., Rahman, M., Pandey, P., Boehme, M.H., Haesaert, G., Eds.; Springer: Berlin/Heidelberg, Germany, 2019; Volume 2, pp. 1–28. [Google Scholar]
- Srinivas, C.; Nirmala, D.D.; Narasimha, M.K.; Dhananjaya, M.C.; Lakshmeesha, T.R.; Singh, B.; Kumar, K.N.; Niranjana, S.R.; Hashem, A.; Alqarawi, A.A.; et al. Fusarium oxysporum f. sp. Lycopersici causal agent of vascular wilt disease of tomato: Biology to diversity—A review. Saudi J. Biol. Sci. 2019, 26, 1315–1324. [Google Scholar] [CrossRef]
- Naranjo-Ortiz, M.A.; Gabaldón, T. Fungal evolution: Cellular, genomic and metabolic complexity. Biol. Rev. 2020, 95, 1198–1232. [Google Scholar] [CrossRef] [PubMed]
- Kamei, A.; Dutta, S.; Sarker, K.; Das, S.; Datta, G.; Goldar, S. Target leaf spot of tomato incited by Corynespora cassiicola, an emerging disease in tomato production under Gangetic alluvial region of West Bengal, India. Arch. Phytopathol. Plant Prot. 2019, 51, 1039–1048. [Google Scholar] [CrossRef]
- Mamode Ally, N.; Neetoo, H.; Ranghoo-Sanmukhiya, M.; Hardowar, S.; Vally, V.; Gungoosingh-Bunwaree, A.; Coutinho, T.A.; Vojvodić, M.; Bulajić, A. First Report of Target Spot on Tomato Caused by Corynespora cassiicola in Mauritius. Plant Dis. 2021, 105, 226. [Google Scholar] [CrossRef]
- Tovar, A.; Hernández, M.; Cristóbal, J.; Romero, R.; Mora, G. Escala logarítmica diagramática de severidad de la mancha negra (Colletotrichum gloeosporioides Penz.) en chirimoyo (Annona cherimola Mill.). Rev. Mex. Fitopatol. 2002, 20, 103–109. Available online: https://www.researchgate.net/publication/237037415_Escala_logaritmica_Diagramatica_de_Severidad_de_la_Mancha_Negra_Colletotrichum_gloeosporioides_Penz_en_Chirimoyo_Annona_cherimola_Mill?enrichId=rgreq-91b6601b3ffea507bca95fe69b294c64-XXX&enrichSource=Y292ZXJQYWdlOzIzNzAzNzQxNTtBUzoxMDQ0MTE1Nzc3MTY3NDJAMTQwMTkwNTA2ODYwNQ%3D%3D&el=1_x_2&_esc=publicationCoverPdf (accessed on 30 June 2022).
- Hernández, L.; Sandoval, J.S. Escala diagramática de severidad para el complejo mancha de asfalto del maíz. Rev. Mex. Fitopatol. 2015, 33, 95–103. Available online: https://www.scielo.org.mx/scielo.php?script=sci_arttext&pid=S0185-33092015000100095 (accessed on 17 July 2022).
- Kustrzeba-Wójcicka, I.; Siwak, E.; Terlecki, G.; Wolańczyk-Mędrala, A.; Mędrala, W. Alternaria alternata and Its Allergens: A Comprehensive Review. Clin. Rev. Allergy Immunol. 2014, 47, 354–365. [Google Scholar] [CrossRef] [PubMed]
- Christias, C.H.; Hatzipapas, P.; Dara, A.; Kaliafas, A.; Chrysanthis, G. Alternaria alternata, a new pathotype pathogenic to aphids. BioControl 2001, 46, 105–124. [Google Scholar] [CrossRef]
- Qi, Y.X.; Zhang, X.; Pu, J.J.; Liu, X.M.; Lu, Y.; Zhang, H.; Xie, Y.X. Morphological and molecular analysis of genetic variability within isolates of Corynespora cassiicola from different hosts. Eur. J. Plant Pathol. 2011, 130, 83–95. [Google Scholar] [CrossRef]
- Voglmayr, H.; Jaklitsch, W.M. Corynespora, Exosporium and Helminthosporium revisited-new species and generic reclassification. Stud. Mycol. 2017, 87, 43–76. [Google Scholar] [CrossRef]
- Sivanesan, A. Graminicolous Species of Bipolaris, Curvularia, Drechslera, Exserohilum and Their Teleomorphs; CAB International: Wallingford, UK, 1987; pp. 141–183. [Google Scholar]
- Wang, M.M.; Chen, Q.; Diao, Y.Z.; Duan, W.J.; Cai, L. Fusarium incarnatum-equiseti complex from China. Pers. Mol. Phylogeny Evol. Fungi 2019, 43, 70–89. [Google Scholar] [CrossRef]
- Ezrari, S.; Lahlali, R.; Radouane, N.; Tahiri, A.; Lazraq, A. First report of Fusarium equiseti causing pre- and postharvest fruit rot on zucchini in Morocco. J. Plant Pathol. 2020, 102, 251. [Google Scholar] [CrossRef]
- Tekpinar, A.D.; Kalmer, A. Utility of various molecular markers in fungal identification and phylogeny. Nova Hedwig. 2019, 109, 187–224. [Google Scholar] [CrossRef]
- Luchi, N.; Ioos, R.; Santini, A. Fast and reliable molecular methods to detect fungal pathogens in woody plants. Appl. Microbiol. Biotechnol. 2020, 104, 2453–2468. [Google Scholar] [CrossRef]
- Crous, P.W.; Rossman, A.Y.; Aime, M.C.; Allen, W.C.; Burgess, T.; Groenewald, J.Z.; Castlebury, L.A. Names of phytopathogenic fungi: A practical guide. Phytopathology 2021, 111, 1500–1508. [Google Scholar] [CrossRef]
- Kingsland, G.C. Pathogenicity and epidemiology of Corynespora cassiicola in the Republic of Seychelles. Int. J. Pest Manag. 1986, 32, 283–287. [Google Scholar] [CrossRef]
- Kingsland, G.C.; Sitterly, W.R. Studies on fungicides for control of Corynespora cassiicola leaf spot of tomatoes in the Republic of Seychelles. Int. J. Pest Manag. 1986, 32, 31–34. [Google Scholar] [CrossRef]
- Robles-Yerena, L.; Ayala-Escobar, V.; Leyva-Mir, S.G.; Bernardi-Lima, N.; Camacho-Tapia, M.; Tovar-Pedraza, J.M. First report of Cladosporium cladosporioides causing leaf spot on tomato in Mexico. J. Plant Pathol. 2019, 101, 759. [Google Scholar] [CrossRef]
- Medina, R.; Franco, M.E.; da Cruz Cabral, L.; Bahima, J.V.; Patriarca, A.; Balatti, P.A.; Saparrat, M.C. The secondary metabolites profile of Stemphylium lycopersici, the causal agent of tomato grey leaf spot, is complex and includes host and non-host specific toxins. Australas. Plant Pathol. 2021, 50, 105–115. [Google Scholar] [CrossRef]
- Tun-Suárez, J.M.; Castillo Peraza, M.E.; Cristóbal Alejo, J.; Latournerie Moreno, L. Etiología de la mancha foliar del chile dulce (Capsicum annuum L.) y su control in vitro en Yucatán, México. Fitosanidad 2011, 15, 5–10. Available online: http://scielo.sld.cu/scielo.php?script=sci_arttext&pid=S1562-30092011000100001 (accessed on 22 June 2022).
- Hernández-Morales, J.; Ochoa-Martínez, D.L.; Ortega-Acosta, S.Á.; Vega-Muñoz, R. Survey on alternative hosts of Corynespora cassiicola, the cause of the leaf and calyx spot, in the surroundings of roselle fields in Mexico. Trop. Plant Pathol. 2018, 43, 263–270. [Google Scholar] [CrossRef]
- Ortega, S.A.; Ochoa, D.L.; Hernández, J.; Palemón, F. Morphological and genetic characterization of Corynespora cassiicola isolates obtained from roselle and associated weeds. Rev. Mex. De Fitopatol. 2020, 38, 1–17. [Google Scholar] [CrossRef]
- Rondon, M.N.; Lawrence, K. The fungal pathogen Corynespora cassiicola: A review and insights for target spot management on cotton and Soya bean. J. Phytopathol. 2021, 169, 329–338. [Google Scholar] [CrossRef]
- Haddoudi, I.; Cabrefiga, J.; Mora, I.; Mhadhbi, H.; Montesinos, E.; Mrabet, M. Biological control of Fusarium wilt caused by Fusarium equiseti in Vicia faba with broad spectrum antifungal plant-associated Bacillus spp. Biol. Control 2021, 160, 104671. [Google Scholar] [CrossRef]
- Khalmuminova, G.K.; Kamilov, S.G.; Verushkina, O.A.; Khujanazarova, M.K. Alternaria diseases of agricultural crops in Uzbekistan. GSC Biol. Pharm. Sci. 2020, 13, 062–067. [Google Scholar] [CrossRef]
- Ferdinandez, H.S.; Manamgoda, D.S.; Udayanga, D. Molecular phylogeny and morphology reveal three novel species of Curvularia (Pleosporales, Pleosporaceae) associated with cereal crops and weedy grass hosts. Mycol. Prog. 2021, 20, 431–451. [Google Scholar] [CrossRef]
- Agrios, G.N. Plant Pathology, 5th ed.; Elsevier Academic Press: Amsterdam, The Netherlands, 2005; pp. 1–838. [Google Scholar]
- Meena, R.; Godika, S.; Yadav, P.D.; Chand, K.; Gayithri, M.; Jajorira, A. Management of early blight of tomato Solanum lycopersicum Mill. Incited by Alternaria solani through salicylic acid in vitro and in vivo. J. Pharm. Innov. 2022, 11, 1–6. Available online: https://www.researchgate.net/publication/360238895_Management_of_early_blight_of_tomato_Solanum_lycopersicum_Mill_Incited_by_Alternaria_solani_through_salicylic_acid_in_vitro_and_in_vivo (accessed on 22 June 2022).
- Pei, Y.; Sun, Y.; Feng, T.; Chen, Y.; Long, H. Pathogen Identification for the New Leaf Spot Disease of Capsicum annuum L. and Its Biological Characteristics. Chin. J. Tropic. Crops CJTC 2021, 42, 2659–2665. [Google Scholar] [CrossRef]
- Thines, M.; Aoki, T.; Crous, P.W.; Hyde, K.D.; Lücking, R.; Malosso, E.; May, T.W.; Miller, A.N.; Redhead, S.A.; Yurkov, A.M.; et al. Setting scientific names at all taxonomic ranks in italics facilitates their quick recognition in scientific papers. IMA Fungus 2020, 11, 25. [Google Scholar] [CrossRef]
- Akbar, A.; Hussain, S.; Ullah, K.; Fahim, M.; Ali, G.S. Detection, virulence and genetic diversity of Fusarium species infecting tomato in Northern Pakistan. PLoS ONE 2018, 13, e0203613. [Google Scholar] [CrossRef]
- Ngegba, P.M.; Kanneh, S.M.; Bayon, M.S.; Ndoko, E.J.; Musa, P.D. Fungicidal effect of three plants extracts in control of four phytopathogenic fungi of tomato (Lycopersicum esculentum L.) fruit rot. Int. J. Environ. Agric. Biotechnol. (IJEAB) 2018, 3, 112–117. [Google Scholar] [CrossRef]
- Manghwar, H.; Hussain, A.; Ali, Q.; Saleem, M.H.; Abualreesh, M.H.; Alatawi, A.; Ali, S.; Munis, M.F.H. Disease severity, resistance analysis, and expression profiling of pathogenesis-related protein genes after the inoculation of Fusarium equiseti in wheat. Agronomy 2021, 11, 2124. [Google Scholar] [CrossRef]
- Safari, Z.S.; Ding, P.; Nakasha, J.J.; Yusoff, S.F. Controlling Fusarium oxysporum tomato fruit rot under tropical condition using both chitosan and vanillin. Coatings 2021, 11, 367. [Google Scholar] [CrossRef]
- Roy, S.; Handique, G.; Muraleedharan, N.; Dashora, K.; Roy, S.M.; Mukhopadhyay, A.; Babu, A. Use of plant extracts for tea pest management in India. App. Microbiol. Biotechnol. 2016, 100, 4831–4844. [Google Scholar] [CrossRef] [PubMed]
- Ngegba, P.M.; Cui, G.; Khalid, M.Z.; Zhong, G. Use of Botanical Pesticides in Agriculture as an Alternative to Synthetic Pesticides. Agriculture 2022, 12, 600. [Google Scholar] [CrossRef]
- Alotibi, F.O.; Ashour, E.H.; Al-Basher, G. Evaluation of the antifungal activity of Rumex vesicarius L. and Ziziphus spina-christi (L) Desf. Aqueous extracts and assessment of the morphological changes induced to certain myco-phytopathogens. Saudi J. Biol. Sci. 2020, 27, 2818–2828. [Google Scholar] [CrossRef]
- Setlow, P. Germination of spores of Bacillus species: What we know and do not know. J. Bacteriol. 2014, 196, 1297–1305. [Google Scholar] [CrossRef]
- Tata, S.; Donli, P.O.; Mohammed, F.K.; Peter, A.; Ahmed, A. Comparative studies on the effect of aqueous and methanolic extracts of some botanicals on growth and sporulation of Colletotrichum graminicola. Int. J. Innov. Res. Adv. Stud. IJIRAS 2018, 5, 1–7. Available online: https://www.ijiras.com/2018/Vol_5-Issue_10/paper_27.pdf (accessed on 5 May 2022).
- Xu, W.H.; Liu, W.Y.; Liang, Q. Chemical constituents from Croton species and their biological activities. Molecules 2018, 23, 2333. [Google Scholar] [CrossRef]
- Pardo-Rodriguez, D.A.; Ortíz-Romero, L.T.; Tacha, A.L.; Murillo-Perea, E.; Mendez-Arteaga, J.J.; Murillo-Arango, W. Estudio químico y etnobotánico de Croton leptostachyus. La Rev. De La Acad. Colomb. De Cienc. Exactas Físicas Y Nat. 2014, 38, 356–363. [Google Scholar]
- Ghosh, P.; Mandal, A.; Rasul, M.G. A new bioactive ursane-type triterpenoid from Croton bonplandianun. Bail. J. Chem. Sci. 2013, 125, 359–364. [Google Scholar] [CrossRef]
- Queiroz, M.M.F.; Queiroz, E.F.; Zeraik, M.L.; Marti, G.; Favre-Godal, Q.; Simões-Pires, C.; Marcourt, L.; Carrupt, M.; Cuendet, M.Q.; Paulo, M.Q.; et al. Antifungals and acetylcholinesterase inhibitors from the stem bark of Croton heliotropiifolius. Phytochem. Lett. 2014, 10, lxxxviii. [Google Scholar] [CrossRef]
- Michereff, S.J.; Noronha, M.D.A.; Andrade, D.E.G.T.D.; Oliveira, E.P.D.; Xavier, F.M.S.; Moreira, P.A.A. Elaboração e validação de escala diagramática para a cercosporiose do pimentão. Summa Phytopathol. 2006, 32, 260–266. [Google Scholar] [CrossRef]
- Ogbebor, N.; Adekunle, A.T. Inhibition of conidial germination and mycelial growth of Corynespora cassiicola (Berk and Curt) of rubber (Hevea brasiliensis muell. Arg.) using extracts of some plants. Afr. J. Biotechnol. 2005, 4, 996–1000. [Google Scholar]
- Garcia, C.; Fedrigo, K.; Gabriel, A.; Botelho, R.V.; Rodrigues, J.D.; Ono, E.O. Control of mildew in vines with cinnamon extract and catalase activity in organic production. Res. Soc. Develop. 2021, 10, e214101018885. [Google Scholar] [CrossRef]
- Arafa, R.A.; Kamel, S.M.; Taher, D.I.; Solberg, S.Ø.; Rakha, M.T. Leaf extracts from resistant wild tomato can be used to control late blight (Phytophthora infestans) in the cultivate tomato. Plants 2022, 11, 1824. [Google Scholar] [CrossRef]
- Kapanen, A.; Itävaara, M. Ecotoxicity tests for compost applications. Ecotoxicol. Environ. Saf. 2001, 49, 1–16. [Google Scholar] [CrossRef]
- Oliveros, A.D.J.; Rodríguez, D.C.; Calcagno, M.P. Estandarización de un bioensayo para la búsqueda de compuestos fitotóxicos en extractos vegetales. Ciencia 2011, 19, 187–202. [Google Scholar]
- Ruiz-Sánchez, E.; Mejía-Bautista, M.Á.; Cristóbal-Alejo, J.; Valencia-Botín, A.; Reyes-Ramírez, A. Actividad antagónica de filtrados de Bacillus subtilis contra Colletotrichum gloeosporioides (Penz.). Rev. Mex. De Cienc. Agrícolas 2014, 5, 1325–1332. [Google Scholar] [CrossRef][Green Version]
- Celis-Perera, S.E.; Moo-Koh, F.A.; Reyes-Ramirez, A.; Suárez, J.M.T.; Cristóbal-Alejo, J. Antagonismo in vitro de Trichoderma asperellum Samuels, Lieckf. & Nirenberg (Ta13-17) contra hongos patógenos de Solanum lycopersicum L. Rev. Prot. Veg. 2021, 36, 1–7. [Google Scholar]
- Elshahawy, I.E.; Haggag, K.H.; Abd-El-Khair, H. Compatibility of Trichoderma spp. with seven chemical fungicides used in the control of soil borne plant pathogens. Res. J. Pharm. Biol. Chem. Sci. 2016, 7, 1772–1785. [Google Scholar]
- Manjunath, M.; Singh, A.; Tripathi, A.N.; Prasanna, R.; Rai, A.B.; Singh, B. Bioprospecting the fungicides compatible Trichoderma asperellum isolate effective against multiple plant pathogens in vitro. J. Environ. Biol. 2017, 38, 553–560. [Google Scholar] [CrossRef]
- Colivet, J.; Belloso, G.; Hurtado, E. Comparación del efecto inhibidor de extractos de ají dulce (Capsicum chinense) sobre el crecimiento de Escherichia coli y Bacillus sp. SABER 2006, 18, 168–173. [Google Scholar]
- Gómez, L.E.; Aguirre, M.C.; Segura, J.D. Evaluación del efecto tóxico de los extractos vegetales acuosos Barbasco (Phyllantus sp.) Neem (Azadirachta indica) y Marigol (Tagetes patula) sobre los microorganismos Trichoderma sp. y Metarhizium sp. Rev. Nataima 2003, 7, 35–40. [Google Scholar]
- Hunter, B.B.; Barnett, H.L. Deuteromycetes (fungi imperfecti). In CRC Handbook of Microbiology; CRC Press: Boca Raton, FL, USA, 2019; pp. 448–476. [Google Scholar]
- Manamgoda, D.S.; Cai, L.; McKenzie, E.H.C.; Crous, P.W.; Madrid, H.; Chukeatirote, E.; Shivas, R.G.; Tan, Y.P.; Hyde, K.D. A phylogenetic and taxonomic re-evaluation of the Bipolaris-Cochliobolus-Curvularia Complex. Fungal Divers. 2012, 56, 131–144. [Google Scholar] [CrossRef]
- White, T.J.; Bruns, T.; Lee, S.; Taylor, J. Amplification and direct sequencing of fungal ribosomal RNA genes for phylogenetics. In PCR Protocols: A Guide to Methods and Applications; Innis, M.A., Gelfand, D.H., Sninsky, J.J., White, T.J., Eds.; Academic Press: San Diego, CA, USA, 1990; p. 315321. [Google Scholar]
- Abbott, W.S. A method of computing the effectiveness of an insecticide. J. Econ. Entomol. 1925, 18, 265–267. [Google Scholar] [CrossRef]
- Schneider, C.A.; Rasband, W.S.; Eliceiri, K.W. NIH Image to ImageJ: 25 years of image analysis. Nat. Methods 2012, 9, 671–675. [Google Scholar] [CrossRef]
- Osada-Velázquez, H.K.; Mora-Aguilera, G. 2LOG Programa para desarrollar escalas de severidad por el método de Horsfall y Barratt. Manual del Usuario. Colegio de Postgraduados, Montecillo, Estado de Mexico, 1997. (Unpublished work). Available online: https://www.colpos.mx/posgrado/assets/pdf/montecillo/fitosanidad/CVU_Fitopatologia/CVU_Gustavo_Mora_Aguilera.pdf (accessed on 11 September 2022).
- Horsfall, J.G.; Barrat, R.W. An improved grading system for measuring plant diseases. Phytopathology 1945, 35, 655. Available online: https://ci.nii.ac.jp/naid/10018788083 (accessed on 12 May 2022).
- Campbell, C.L.; Madden, L.V. Introduction to Plant Disease Epidemiology; John Wiley and Sons: New York, NY, USA, 1990; p. 532. [Google Scholar]
- Basurto-Cadena, M.G.L.; Vázquez-Arista, M.; García-Jiménez, J.; Salcedo-Hernández, R.; Bideshi, D.K.; Barboza-Corona, J.E. Isolation of a new Mexican strain of Bacillus subtilis with antifungal and antibacterial activities. Sci. World J. 2012, 2012, 384978. [Google Scholar] [CrossRef]

| Strain ID | Length (µm) | Width (µm) | Species |
|---|---|---|---|
| ITC24 | 17–36 | 7–12 | Alternaria alternata |
| ITC23 | 10–28 | 1–17 | Corynespora cassiicola |
| ITC22 | 18–32 | 8–16 | Curvularia lunata |
| ITC32 | 20–83 | 3–6 | Fusarium equiseti |
| Strain ID | Source | Molecular Identification | ||
|---|---|---|---|---|
| Species | Similarity (%) a | GenBank Accession | ||
| ITC24 | Leaves | Alternaria alternata | 100 | ON815355 |
| ITC23 | Leaves | Corynespora cassiicola | 100 | ON815356 |
| ITC22 | Leaves | Curvularia lunata | 100 | ON804206 |
| ITC32 | Fruit base | Fusarium equiseti | 99 | ON815354 |
| Plant Species | Plant Part | Alternaria alternata (ITC24) | Corynespora cassiicola (ITC23) | Curvularia lunata (ITC22) | Fusarium equiseti (ITC32) |
|---|---|---|---|---|---|
| Acalypha gaumeri | root | 0 d | 7.1 h | 1.2 f | 0 e |
| Bonellia flammea | stem bark | 0 d | 27.3 d | 93.7 b | 8.1 c |
| Croton chichenensis | root | 0 d | 100 a | 99.2 a | 100 a |
| Calea jamaicensis | whole plant | 0 d | 5.7 h | 0 g | 0 e |
| Licaria sp. | leaves | 0 d | 2.4 i | 22.1 cd | 2.3 d |
| root bark | 0 d | 6.5 h | 4.9 e | 0 e | |
| stem bark | 0 d | 15.5 ef | 4.8 e | 0 e | |
| Mosannona depressa | root bark | 2.4 c | 12.4 g | 24.7 cd | 7.9 c |
| stem bark | 35.9 a | 48.9 b | 19.5 d | 44.6 b | |
| Parathesis cubana | stem bark | 0 d | 37.9 c | 7.8 e | 2.2 d |
| Piper neesianum | leaves | 10.2 b | 13.8 fg | 28.7 c | 0 e |
| Control (water) | 0 d | 0 j | 0 g | 0 e |
| Species | Plant Part | Alternaria alternata (ITC24) | Corynespora cassiicola (ITC23) | Curvularia lunata (ITC22) | Fusarium equiseti (ITC32) |
|---|---|---|---|---|---|
| Acalypha gaumeri | root | 100 a | 0 e | 100 a | 89.9 c |
| Bonellia flammea | stem bark | 100 a | 83.4 b | 100 a | 93.3 b |
| Croton chichenensis | root | 100 a | 100 a | 100 a | 100 a |
| Calea jamaicensis | whole plants | 100 a | 10.5 d | 0 d | 0 f |
| Licaria sp. | leaves | 100 a | 99.5 a | 0 d | 49.5 e |
| root bark | 89.1 b | 0 e | 90.1 c | 0 f | |
| stem bark | 100 a | 20.7 c | 96.8 b | 100 a | |
| Mosannona depressa | root bark | 27.7 c | 21.7 c | 100 a | 69.9 d |
| stem bark | 100 a | 0 e | 100 a | 0 f | |
| Parathesis cubana | stem bark | 0 d | 0 e | 0 d | 0 f |
| Piper neesianum | leaves | 27.7 c | 21.7 c | 100 a | 69.9 d |
| Control (water) | 0 d | 0 e | 0 d | 0 f |
| Species | Plant Part | Alternaria alternata (ITC24) | Corynespora cassiicola (ITC23) | Curvularia lunata (ITC22) | Fusarium equiseti (ITC32) |
|---|---|---|---|---|---|
| Acalypha gaumeri | root | 0.0 b | 0.0 f | 100 a | 100 a |
| Bonellia flammea | stem bark | 0.0 b | 20.3 d | 98.9 a | 100 a |
| Croton chichenensis | root | 80.9 a | 100 a | 100 a | 70.5 b |
| Calea jamaicensis | whole plants | 0.0 b | 11.3 e | 0.0 c | 0.0 d |
| Licaria sp. | leaves | 0.0 b | 100 a | 0.0 c | 0.0 d |
| root bark | 0.0 b | 0.0 f | 85.2 b | 0.0 d | |
| stem bark | 0.0 b | 19.9 d | 100 a | 100 a | |
| Mosannona depressa | root bark | 0.0 b | 80.1 c | 100 a | 61.3 c |
| stem bark | 0.0 b | 83.7 b | 100 a | 0.0 d | |
| Parathesis cubana | stem bark | 0.0 b | 0.0 f | 0.0 c | 0.0 d |
| Piper neesianum | leaves | 0.0 b | 80.1 c | 100 a | 61.3 c |
| Control (water) | 0.0 b | 0 f | 0.0 c | 0.0 d |
| Treatment | AUDPC (%/Day) | Yfinal (%) | Weibull Tasa 1/b (%/Day) | r2 Coefficient of Determination |
|---|---|---|---|---|
| Extract | 64.56 b | 10.43 b | 0.01901 b | 0.98 |
| Control-water | 1057.01 a | 67.59 a | 0.03012 a | 0.96 |
| Species | Family | Site | Voucher | Part |
|---|---|---|---|---|
| Acalypha gaumeri Pax & K. Hoffm | Euphorbiaceae | Yaxcabá | PS-2584 | root |
| Bonellia flammea (Millsp. ex Mez) B. Ståhl & Källersjö | Primulaceae | Yaxcabá | PS-2782 | stem bark |
| Croton chichenensis Lundell | Euphorbiaceae | Baca | PS-2571 | root |
| Calea jamaicensis (L.) L. | Asteraceae | Jahuactal | GC-8084 | whole plant |
| Licaria sp. | Lauraceae | Jahuactal | GC-8037 | leaves |
| root bark | ||||
| stem bark | ||||
| Mosannona depressa (Ball.) Chatrou | Annonaceae | Jahuactal | GC-8085 | root bark |
| stem bark | ||||
| Parathesis cubana (A. DC.) Molinet & M. Gómez | Primulaceae | Jahuactal | JLT-1133 | stem bark |
| Piper neesianum C .DC. | Piperaceae | Jahuactal | GC-8080 | leaves |
Publisher’s Note: MDPI stays neutral with regard to jurisdictional claims in published maps and institutional affiliations. |
© 2022 by the authors. Licensee MDPI, Basel, Switzerland. This article is an open access article distributed under the terms and conditions of the Creative Commons Attribution (CC BY) license (https://creativecommons.org/licenses/by/4.0/).
Share and Cite
Moo-Koh, F.A.; Cristóbal-Alejo, J.; Tun-Suárez, J.M.; Medina-Baizabal, I.L.; Arjona-Cruz, A.A.; Gamboa-Angulo, M. Activity of Aqueous Extracts from Native Plants of the Yucatan Peninsula against Fungal Pathogens of Tomato In Vitro and from Croton chichenensis against Corynespora cassiicola on Tomato. Plants 2022, 11, 2821. https://doi.org/10.3390/plants11212821
Moo-Koh FA, Cristóbal-Alejo J, Tun-Suárez JM, Medina-Baizabal IL, Arjona-Cruz AA, Gamboa-Angulo M. Activity of Aqueous Extracts from Native Plants of the Yucatan Peninsula against Fungal Pathogens of Tomato In Vitro and from Croton chichenensis against Corynespora cassiicola on Tomato. Plants. 2022; 11(21):2821. https://doi.org/10.3390/plants11212821
Chicago/Turabian StyleMoo-Koh, Felicia Amalia, Jairo Cristóbal-Alejo, José María Tun-Suárez, Irma Leticia Medina-Baizabal, Alejandra Anahi Arjona-Cruz, and Marcela Gamboa-Angulo. 2022. "Activity of Aqueous Extracts from Native Plants of the Yucatan Peninsula against Fungal Pathogens of Tomato In Vitro and from Croton chichenensis against Corynespora cassiicola on Tomato" Plants 11, no. 21: 2821. https://doi.org/10.3390/plants11212821
APA StyleMoo-Koh, F. A., Cristóbal-Alejo, J., Tun-Suárez, J. M., Medina-Baizabal, I. L., Arjona-Cruz, A. A., & Gamboa-Angulo, M. (2022). Activity of Aqueous Extracts from Native Plants of the Yucatan Peninsula against Fungal Pathogens of Tomato In Vitro and from Croton chichenensis against Corynespora cassiicola on Tomato. Plants, 11(21), 2821. https://doi.org/10.3390/plants11212821

